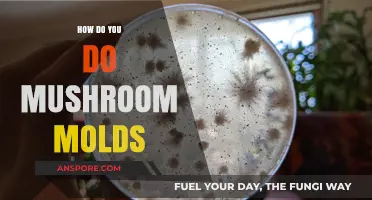
Growing Mushrooms: Mastering the Art of Mushroom Molds

Fruit flies are a common problem for mushroom growers. They can destroy a crop, leaving mushrooms brown, leathery, and inedible. The Sciarid fly, also known as the fungus gnat, is the most pervasive pest for many growers. The Phorid fly and Cecid fly are other common pests. To prevent and remove the threat of fruit flies, growers can use methods such as pasteurization, introducing natural predators, and setting traps.
| Characteristics | Values |
|---|---|
| Prevention | Sanitation, exclusion, cleanliness, airtight mushroom houses with filtered air vents, positive pressure zones, water management, adequate indoor ventilation, additives as deterrents (citronella candles, crushed tansy leaves), pasteurization of the soil medium, bug zappers, yellow flypaper strips, diatomaceous earth, removal of infected casings, cleaning the growing area |
| Treatment | Chemicals, natural predators (Venus flytraps, green tree frogs, praying mantises), biological controls (mites, worms, wasps), insecticides, insecticidal soap, pyrethrin |
Explore related products
What You'll Learn

Use natural predators like frogs, mites, worms, or wasps
Natural predators such as frogs, mites, worms, or wasps can be used to control fruit flies in mushrooms. This method, known as "biologicals," involves employing living organisms to work for you in managing pest populations.
One option is to introduce frogs, such as the green tree frog, which will happily feed on flies. However, it is important to ensure that the frogs themselves are not carrying any unwanted pests or diseases. Praying mantises can also be used, but it is recommended to use the young, freshly hatched from egg cases, as the adults can be quite large and intimidating.
Another option is to release predatory mites, such as Hypoaspis miles, which will feed on the fruit fly larvae. Mites can be used both for prevention and damage control. Approximately 10 mites per square foot are recommended for prevention, while 30-50 mites per square foot are suggested for damage control.
Predatory nematodes, such as Steinernema feltiae, are another natural predator that can be employed. These tiny worms live in the water-coated spaces between soil particles. They have a specialized infective juvenile stage that attacks insects, entering through natural openings and releasing bacteria that kill the host within 24 hours. Nematodes then feed on the remains and complete multiple generations inside the host before moving on to new hosts.
Parasitic wasps, such as Synacra pauperi, are also effective biological control agents for fruit flies. The parasitized larvae die after pupation, but it is important to note that the parasitized larvae may still cause some damage before death. Wasps are particularly useful in preventing infestations and are commonly used in Swedish greenhouses to reduce the need for insecticides.
In addition to these natural predators, other preventive measures can be taken, such as maintaining strict sanitation, exclusion, and cleanliness in mushroom-growing areas. Pasteurization of the substrate or soil before cultivation can also help eliminate pests.
Mushrooms: A Rich Source of Polyphenols?
You may want to see also

Employ insecticides and pesticides
Insecticides and pesticides are effective ways to deal with fruit flies in mushrooms. However, it is important to note that not all insecticides and pesticides are suitable for use on mushrooms meant for human consumption. Diazinon, for instance, was once the most effective pesticide for mushroom phorid flies, but it is no longer approved for use on mushroom farms.
When using insecticides, it is important to identify the type of fly or pest you are dealing with, as different insects have different life cycles and behaviours, and may require different control methods. For example, the cecid fly is rarely seen as the larvae reproduce within the body of a 'mother' larva, and the flies are very small. On the other hand, sciarid flies, also called fungus gnats, are one of the most common and damaging insects encountered when growing mushrooms indoors.
To prevent flies, it is recommended to maintain strict sanitation and farm cleanliness. Air filters and air exchange can also help provide fresh air to mushrooms while preventing the entry of pests.
When using insecticides, it is important to follow the instructions on the product label and take the necessary safety precautions. Some insecticides may be harmful to humans and the environment, so it is advisable to opt for organic or natural alternatives whenever possible. For example, organic fungicides like neem oil or copper-based solutions can be used to prevent fungal diseases. Other natural remedies include using beneficial insects and organisms, such as predatory mites, to control sciarid flies.
If you are dealing with a mushroom phorid fly infestation, it is important to note that exclusion is the most effective way to reduce their population. Close windows, doors, and other openings to the outside, and close blinds at night to hide the light, which attracts these flies. Vacuuming the flies and using sticky traps on windows and light traps in homes may also help reduce their numbers.
In terms of specific insecticides, Diflubenzuron (Dimilin) is an insect growth regulator that inhibits the production of chitin in the larvae, preventing their moulting process. However, cases of insect resistance to Diflubenzuron have been observed. Azadirachtin (Diazinon) can be applied to mushroom house walls and floors, but it has been withdrawn from use in many areas due to fly resistance. Other insecticides mentioned include Permethrin, Piperonyl butoxide, and Pyrethrins, which are used to fog mushroom houses for flies when mushrooms are not present.
For newly spawned substrates, it is recommended to use aerosols, smoke, and fine-dispersed applications of allowed pesticides. When using insecticides in compost, it is crucial to mix and distribute the compound evenly, and to keep the insecticide and the mycelium as far from each other as possible during the spawning process, as the insecticide can adversely affect mycelium growth and fruit body formation.
Mushrooms' Secret Tree Talk: Unveiling Their Communication
You may want to see also

Use traps and repellents
Fruit flies are attracted by the smell of compost and growing mycelium. They enter the growing rooms through openings and cracks and lay eggs in the substrate, casing layer, and on fruit bodies. The best way to control flies is through strict sanitation, exclusion, and farm cleanliness. Mushroom houses must be airtight, and all air vents must have filters. Using traps and repellents is an effective way to deal with fruit flies in mushrooms. Here are some methods to consider:
Traps
- Hang traps to catch the fruit flies.
- Use a bug zapper to electrically trap and kill the flies.
- Set up yellow flypaper strips vertically near the mushroom trays to trap flies.
- Use a Venus flytrap, which will survive in a humid grow room and eat the flies.
- Introduce praying mantises (tinodera sinesis) to eat the flies.
Repellents
- Use citronella candles, which are reputed to repel many flying insects, including fruit flies.
- Sprinkle crushed leaves of the herb 'tansy' around the growing area. In the past, meat was packed in tansy to prevent decay and repel flies.
- Employ biological controls by introducing natural predators such as frogs or mites, worms, or wasps to eat the flies and their eggs.
- Use insecticides or pesticides allowed for mushroom growing. For example, Safer® Brand Insecticidal Soap & Pyrethrin is a concentrate that can be sprayed on walls and the floor of the mushroom house to attack insects' nervous systems and weaken their outer shells.
- Diatomaceous earth can be used as a repellent and also deters slugs and snails in outdoor beds.
- Pasteurise the substrate to prevent the presence of mushroom flies. This will eliminate any pests present in the substrate before cultivation.
Weighing Your Mushrooms: 3 oz Portion Size
You may want to see also
Explore related products

Maintain strict sanitation, exclusion, and cleanliness
Maintaining strict sanitation, exclusion, and cleanliness is the best way to control flies. To achieve this, mushroom houses must be airtight with filtered air vents. It is also beneficial to create a positive pressure zone with filters on all air intakes to prevent pests. Proper sanitation methods in mushroom farming require the pasteurization of the soil medium before a fresh crop can be grown. This eliminates insects, nematodes, pest fungi, and other pests in the compost.
To properly pasteurize compost for mushroom production, its temperature must be raised to 140 degrees Fahrenheit for at least four hours. Higher temperatures will kill or deactivate beneficial microbes needed for later growth processes. Different types of compost require different pasteurization methods. For example, straw is heated in water, while other types of compost are steamed or have dry heat applied. While pasteurization protects the early growth of mushrooms, it will not prevent invaders from outside sources.
In addition to pasteurization, proper waste management is crucial to controlling fungus gnat buildups. This includes avoiding overwatering and providing adequate indoor ventilation. Moving air is not conducive to fungus gnats. It is also important to ensure that substrates are properly prepared, as flies usually originate from improperly prepared substrates. If an infestation occurs, it is important to clean the grow space thoroughly.
Mushroom Carbonara: Which Fungi to Choose?
You may want to see also

Pasteurise the substrate
Pasteurising the substrate is a crucial step in mushroom cultivation. It helps eliminate harmful competitor organisms that thrive in the same moist, nutrient-rich environment as the mushroom mycelium. By pasteurising the substrate, you create an environment conducive to the growth of the mushroom mycelium, giving it a head start and allowing it to spread throughout the substrate before other contaminants, such as mould or bacteria, can take over.
The process of pasteurisation involves heating the substrate to a specific temperature range for a set period. The temperature range for pasteurisation is typically between 140°F to 160°F (60°C to 71°C). Maintaining the temperature within this range is crucial for killing harmful bacteria, fungi, and pests while preserving beneficial microorganisms that support healthy mycelium growth.
There are different methods for pasteurising a substrate, including heat and cold techniques. For example, one method involves preheating your oven to 93°C and placing your compost in a baking tray. Use a thermometer to monitor the temperature of the soil, and when it reaches 71°C, let it bake for 30 minutes. Other methods include steaming the substrate or applying dry heat, depending on the type of compost used. Straw, for instance, is usually heated in water.
It is important to note that pasteurisation is not sterilisation. Sterilising the substrate kills all organisms, leaving a blank canvas for anything to grow. In contrast, pasteurisation reduces the number of harmful competitor organisms, creating a microbial balance that supports healthy mycelium growth. The choice between pasteurisation and sterilisation depends on the specific requirements of the mushroom species and the grower's preferences.
By pasteurising your substrate, you can effectively prevent the presence of mushroom flies and eliminate pests already present in your substrate before cultivation begins. This step ensures a healthy environment for your mushrooms to thrive without competition from other organisms.
Trip Killing Mushrooms: A Step-by-Step Guide
You may want to see also
Frequently asked questions
To prevent fruit flies, sanitation is key. Pasteurising the substrate is an efficient way to prevent flies. To do this, preheat your oven to 93 degrees Celsius. Put some compost into a baking tray and monitor the temperature of the soil. When the soil reaches 71 degrees Celsius, bake for 30 minutes.
Fruit flies are attracted to the smell of compost and growing mycelium. They enter growing rooms through openings and cracks and lay eggs into the substrate, casing layer and on fruit bodies. Larvae appear after 5-10 days and cause damage to the mushrooms.
Larvae feed on mushroom mycelium and gnaw the pins. Young mushrooms become hollow and shrink or die. Mushrooms lose their marketable appearance because of the larvae that swarm on their surface.
To get rid of fruit flies, burn, bury or drown the infested substrate away from your grow area. Then clean your grow space thoroughly. You can also use insecticides, but be sure to keep them away from the mycelium as they can have an adverse effect on the subsequent growth.